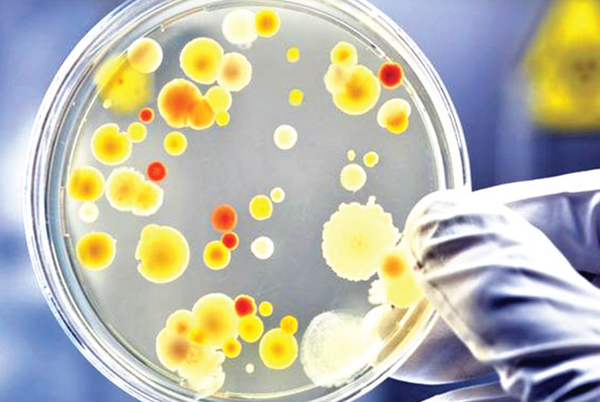
From foes to friends – bacteria join the fight against cancer

New discovery could be a step towards future immunotherapy for brain cancer
In 10 seconds? Researchers have found novel structures near brain tumours that can be used to provoke an immune response against cancer cells. This could open the way for more effective treatment with fewer side effects in the fut...